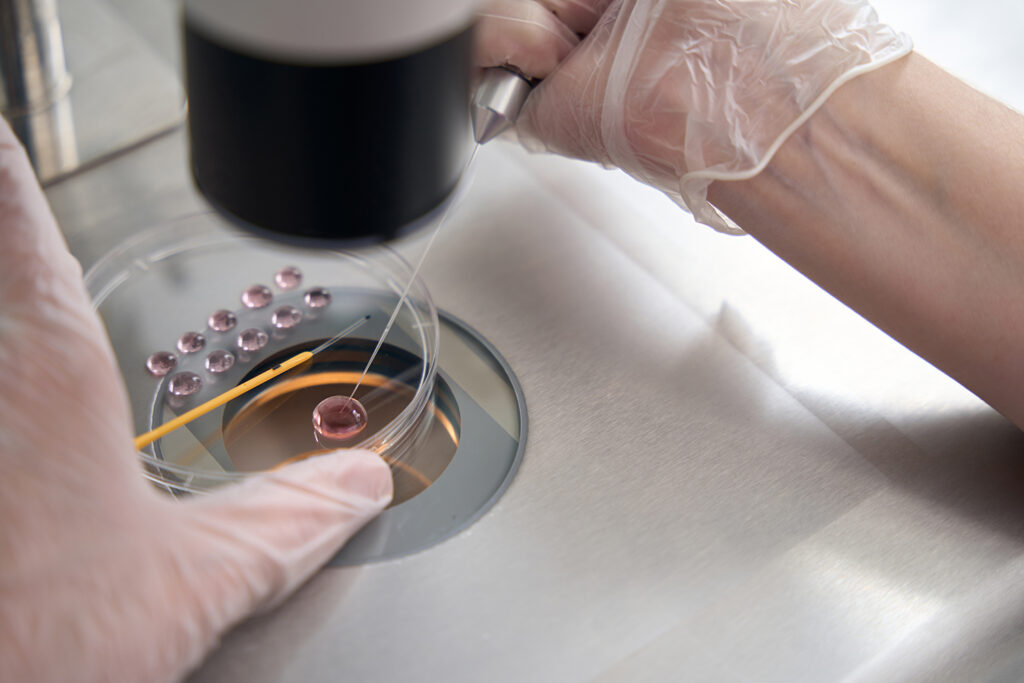

Kompleksowy szkolenie z embriologii ludzkiego organizmu – od zapłodnienia do porodu z wzięciem pod uwagę stadiów formowania się embrionalnego i przedurodzeniowego
Embriologia – bazowy element pojęcia osobowego życia
Embriologia, jako gałąź badawcza zajmująca się procesem zarodkowym człowieka i innych jednostek biologicznych, odgrywa ważną rolę w medycynie, nauce o życiu i obszarach przyrodniczych. Wiedza na temat podstaw embriologii jest nie tylko koniecznością w programach nauczania specjalistów i przyrodników, ale również przyczynia się do głębszego poznania wielu zaburzeń wrodzonych, metod wspomaganego rozrodu, a także rozwoju w dziedzinie bioinżynieryjnej. Z tego przyczyny nasilają się zainteresowanie na profesjonalne kursy z embriologii, które spełniają dzisiejszym wymaganiom kształcenia uczniów i specjalistów.
Znaczenie embriologii w naukach medycznych
Proces wewnątrzmaciczny to wyjątkowo złożony mechanizm, który zaczyna się od fertylizacji, a kończy przyjściem na świat w całkowicie ukształtowanego noworodka. Każdy etap tego ciągu – od segmentacji, przez tworzenie listków zarodkowych, formowanie cewy nerwowej, aż po tworzenie narządów – ma podstawowe znaczenie biologiczne dla prawidłowego rozwoju organizmu. Zaburzenia na którymkolwiek etapie mogą wywoływać poważnych anomalii rozwojowych. Wiedza embriologiczna jest konieczna specjalistom, specjalistom rozrodu, akuszerkom, biologom laboratoryjnym, genetykom, specjalistom ontogenezy, a nawet specjalistom kryminalistyki. Z tego względu coraz więcej uczelni szkolnictwa wyższego oraz centrów nauczających oferuje specjalistyczne szkolenie z embriologii https://med-coach.pl/kadra/jean-paul-hoppner/73 w postaci dokształcania dla absolwentów lub uzupełniającego.
Dla kogo przeznaczony jest kurs embriologii?
Kurs embriologii dedykowany jest dla rozległego kręgu zainteresowanych. Biorą udział w nim zarówno osoby uczące się specjalizacji zdrowotnych i naukowych, jak i już zatrudnieni lekarze, analitycy medyczni czy osoby zatrudnione w instytucjach in vitro. W zależności od etapu skomplikowania, kurs z embriologii może obejmować elementarne informacje o ontogenezie albo szczegółowe tematy obejmujące procedurami in vitro, rozpoznaniem przedimplantacyjną czy najnowszymi badaniami z dziedziny rozwoju zarodkowego.
Dlaczego warto wziąć udział w szkoleniu z embriologii?
Obecność w profesjonalnym szkoleniu z embriologii umożliwia nabycie kompleksowej informacji teoretycznej oraz – w przypadku niektórych kursów – manualnych umiejętności. Dla osób zatrudnionych w placówkach naukowych duże znaczenie mają lekcje manualne, takie jak sprawdzanie klasy oocytów, komórek rozwijających się czy transfer zarodka. kurs embriologii jest również szczególnie ważny dla tych, którzy aspirują do pracy w branży medycyny rozrodu. Umiejętność rozpoznawania indywidualnych etapów rozwoju zarodka, klasyfikacja jego potencjału biologicznego oraz zastosowanie zaawansowanych technik badawczych – to tylko niektóre z umiejętności, jakie można opanować podczas kursu z embriologii.